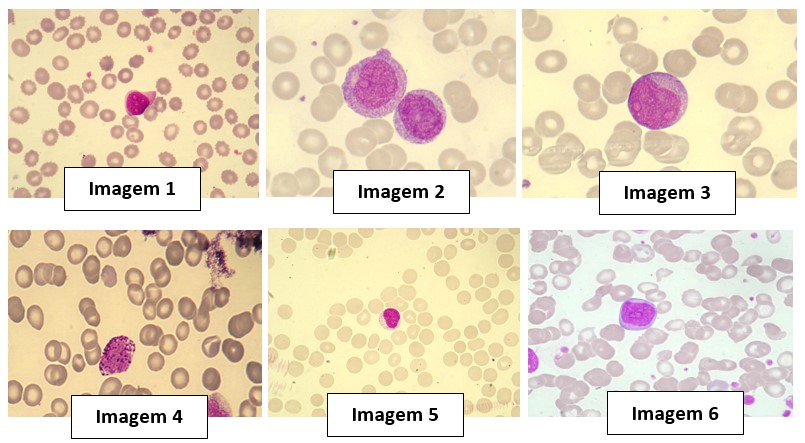

DESENVOLVENDO O TRABALHO
Com todas as informações expostas acima, é hora de agir!
Caso Clínico
As leucemias são tipos de câncer que afetam os glóbulos brancos, células responsáveis pela defesa do organismo. Elas se originam na medula óssea, onde ocorre a produção dessas células, e podem ser classificadas conforme a velocidade de progressão e o tipo de célula afetada. Os sintomas incluem fadiga, anemia, infecções recorrentes, febre, perda de peso, sangramentos espontâneos, manchas roxas na pele (petéquias) e aumento do baço e fígado. O tratamento varia conforme o tipo de leucemia e pode incluir quimioterapia, radioterapia, imunoterapia, terapias-alvo, entre outros.
Fonte: https://abrale.org.br/noticias/mobilizacao-na-ajuda-a-quem-tem-linfoma-e-leucemia/. Acesso em: 21 jan. 2025.
Como parte da contextualização da atividade Mapa, primeiramente você deverá acessar o link a seguir para assistir ao vídeo que apresenta um caso clínico real.
Segue o link: https://www.youtube.com/watch?v=qdG8RUFsId4

ETAPA 1
Instruções para a realização deste item:
- A execução da etapa 1 NÃO está vinculada à prática presencial no polo.
- Para as respostas da etapa 1 (itens 1.1, 1.2, 1.3, 1.4, 1.5 e 1.6), você precisará analisar as questões abaixo e aplicar os conhecimentos teóricos referente ao conteúdo da disciplina.
Em relação ao caso clínico apresentado, responda as questões abaixo:
Em pacientes leucêmicos, é muito comum observar a queda de hemoglobina nos laudos de hemograma, principalmente em leucemias agudas. Com relação a essa alteração, DESCREVA a relação da queda de hemoglobina com a leucemia.
Apague este texto em vermelho e coloque aqui apenas a sua resposta
Podemos observar várias vezes no vídeo que a mãe cita a palavra "blasto", indicando que é uma célula encontrada comumente em leucemias. Com relação aos blastos, DEFINA o que são e APRESENTE as características morfológicas observadas durante a análise microscópica para definição da célula.
Apague este texto em vermelho e coloque aqui apenas a sua resposta
Existem vários tipos de leucemia, as quais podem ser classificadas como a linhagem celular afetada ou evolução da doença, por exemplo. A paciente do vídeo foi diagnosticada com leucemia linfoide aguda (LLA). Com relação a essa doença, EXPLIQUE as principais características celulares e fisiológicas da LLA.
Apague este texto em vermelho e coloque aqui apenas a sua resposta
O cromossomo Philadelphia (Ph) pode ser encontrado em algumas condições leucêmicas. No vídeo, a mãe relata que os exames da filha apresentaram “positivo para Ph”. INTERPRETE o que significa esse achado e EXPLIQUE a base genética envolvida.
Apague este texto em vermelho e coloque aqui apenas a sua resposta
Das fotos a seguir, INDIQUE quais seriam os prováveis blastos:
Fonte: o autor.
A percepção das características laboratoriais das doenças hematológicas, visualizadas no hemograma, é de fundamental importância para o seu correto diagnóstico. Você deve usar como base para elaborar as respostas o livro didático e livros de hematologia, além das práticas correspondentes do Material Didático Digital (MDD) e do Laboratório Virtual de Hematologia, apresentados como material complementar de pesquisa.
Sabendo disso, AVALIE os resultados dos nove pacientes, apresentados no Laboratório Virtual – Diferencial Leucocitário e Leucemias, colocando a classificação de cada um na tabela abaixo. EXPLIQUE quais características hematimétricas representam o provável diagnóstico:
Preencha a tabela abaixo com suas respostas
|
Paciente |
Resultado |
Características hematimétricas |
|
1 |
|
|
|
2 |
|
|
|
3 |
|
|
|
4 |
|
|
|
5 |
|
|
|
6 |
|
|
|
7 |
|
|
|
8 |
|
|
|
9 |
|
|
ITEM 2
Instruções:
- Os itens 2.1, 2.2, 2.3 e 2.4 serão realizados durante o Encontro Prático Presencial no LPI do seu polo. A prática corresponde à disciplina de Hematologia Clínica – CONTAGEM DE HEMÁCIAS E CONTAGEM DE LEUCÓCITOS, prevista para ocorrer na semana 5 do módulo (24/03 a 01/04/2025), mediante agendamento em seu Studeo.
- ATENÇÃO! Os agendamentos ocorrem na semana que ANTECEDE a prática, desta forma, o agendamento está previsto para a semana 4 do módulo (17 a 21/03/2025).
- Leia com antecedência as informações sobre a prática correspondente no MDD (Material Didático Digital), que estará disponível no fórum da disciplina.
CONTEXTUALIZAÇÃO
A contagem das células sanguíneas desempenha um papel fundamental na interpretação do hemograma. Existem várias técnicas de contagem celular, que vão desde equipamentos totalmente automatizados até a utilização de instrumentos laboratoriais como a câmara de Neubauer, que permite a quantificação de células em líquidos como sangue e urina. Para isso, uma amostra de sangue total é preparada, diluída e aplicada na câmara para posterior análise microscópica. Durante a análise, o microscópio é ajustado conforme o material analisado, para que assim possa ocorrer uma avaliação minuciosa das células. Dessa forma, é possível determinar o valor total de leucócitos em uma amostra de sangue.
Elaborado pelo professor.
Com relação à análise do sangue para a realização da contagem manual de hemácias e leucócitos, EXECUTE os comandos a seguir:
2.1) Ao iniciar a prática, organize a bancada com os insumos necessários, TIRE UMA FOTO e ANEXE no modelo de resposta padrão.
Apague este texto em vermelho e coloque aqui a IMAGEM.
2.2) Sobre a contagem global de hemácias e leucócitos, DESCREVA cada etapa das técnicas, bem como a realização correta da microscopia e EXPLIQUE a finalidade do reagente de Türk e reagente de Hayem.
Apague este texto em vermelho e coloque aqui apenas a sua resposta
2.3) Considerando a importância da elaboração correta dos laudos laboratoriais, após a realização da sua contagem manual de hemácias e leucócitos, INSIRA os resultados obtidos, considerando os cálculos de ajuste dos fatores de diluição no modelo de laudo abaixo.
LAUDO:
Identificação da amostra:
Data:
Metodologia:
Resultados:
Contagem Global de Hemácias: Preencha aqui com sua resposta Milhões/mm3
Valor de referência:
Homem adulto: 4,5 - 5,9 Milhões/mm³.
Mulher adulta: 4,0 - 5,2 Milhões/mm³.
Recém-nascidos: 3,9 - 6,0 Milhões/mm³.
Contagem Global de Leucócitos: Preencha aqui com sua resposta /mm3
Valor de referência:
Recém-nascido - 9.400 – 34.000/mm³
Adultos: 5.000 – 10.000/mm³
2.4) ANEXE uma foto evidenciando você, como estudante, executando as técnicas de contagens totais de hemácias e leucócitos.
Apague este texto em vermelho e coloque aqui a IMAGEM.
REFERÊNCIAS
Insira aqui as referências que você utilizou para responder a este trabalho dentro das normas da ABNT. Você também poderá utilizar o manual institucional para elaboração de referências disponível para download em ARQUIVOS GERAIS no menu lateral
| 1 x de R$49,99 sem juros | Total R$49,99 |









